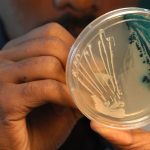

Le Bénin est actuellement en discussions avec le Rwanda pour qu’il lui fournisse un soutien logistique et une expertise dans sa lutte contre le jihadisme dans le nord, a déclaré vendredi à l’AFP le porte-parole de la présidence béninoise.
L’armée béninoise est déployée dans la région septentrionale pour contenir les groupes jihadistes présents chez ses voisins nigérien et burkinabé, qui y mènent des incursions et attaquent les forces de sécurité. Elle cherche actuellement à renforcer son dispositif sécuritaire.
« Comme avec le Niger et le Burkina Faso, nous discutons avec le Rwanda pour l’appui logistique et la fourniture d’une expertise », a confirmé le porte-parole de la présidence Wilfried Houngbédji. « Mais l’accord à venir ne prévoit pas de déploiement au sol de troupes rwandaises », a-t-il ajouté.
Cette précision fait suite à la publication d’un article de Africa Intelligence, un média d’information spécialisé sur l’Afrique, qui rapporte que des « négociations secrètes entre Kigali et Cotonou » sont en cours pour le déploiement de plusieurs centaines de soldats et d’experts rwandais dans le nord du Bénin.
« Le nombre d’éléments rwandais qui devraient être projetés, dans un premier temps, est estimé à 350. Un chiffre qui pourrait ensuite doubler », selon les informations de ce média, qui précise que les négociations viennent d’entrer dans leur phase finale.
« Je ne peux pas faire de commentaire à ce sujet, mais ce que je peux confirmer, c’est qu’il existe une coopération en matière de défense entre nos deux pays », a déclaré Ronald Rwivanga, porte-parole des forces de défense du Rwanda, interrogé par l’AFP.
Le chef d’état-major des forces armées béninoises, le général Fructueux Gbaguidi, s’était rendu en juillet dernier au Rwanda pour des entretiens bilatéraux visant à approfondir les relations existantes entre les deux armées, selon un communiqué du ministère rwandais de la Défense. Les pays côtiers, comme le Bénin, le Togo, le Ghana et la Côte d’Ivoire, cherchent à renforcer leur dispositif militaire pour sécuriser leurs frontières avec le Mali, le Niger et le Burkina Faso, après une série de raids.
Ils s’inquiètent désormais de possibles recrutements des groupes jihadistes au sein des populations. L’année dernière, l’armée rwandaise a déployé environ 1.000 soldats dans le nord du Mozambique pour aider Maputo dans sa lutte antijihadiste. Selon certaines sources, les troupes rwandaises ont été parmi les plus efficaces et sont les plus fréquemment déployées pour des opérations de combat dans le nord du Mozambique.
AFP